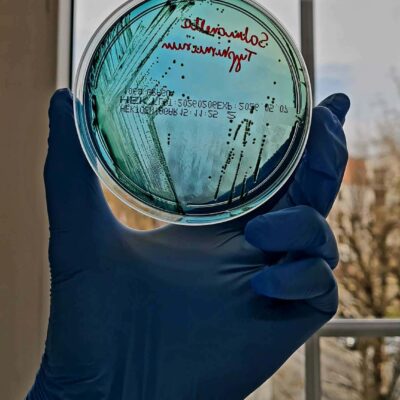

10 kwietnia uczniowie klasy 7a odwiedzili Powiatową Stację Sanitarno-Epidemiologiczną w Lubinie. W programie znalazło się zwiedzanie laboratorium, praca z mikroskopem oraz praktyczne ćwiczenia dotyczące higieny mycia rak, dzięki specjalnemu urządzeniu każdy mógł sprawdzić, jak dokładnie umył dłonie.
Sporo emocji wywołał także eksperyment z alkogoglami i narkogoglami, które pokazały, jak zmienia się percepcja pod wpływem różnych substancji. Uczniowie zobaczyli również sprzęt do poboru próbek wody i zajrzeli do miejsc, gdzie na co dzień pracownicy sanepidu dbają o zdrowie mieszkańców. To była ciekawa lekcja w praktyce, pozwalająca uczniom zobaczyć, jak wygląda praca w PSSE od środka.